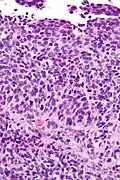
Very high mag.

Transitional cell carcinoma of the ovary
| Transitional cell carcinoma of the ovary | |
|---|---|
 | |
| Micrograph of transitional cell carcinoma of the ovary. H&E stain. |
Transitional cell carcinoma of the ovary (TCC of the ovary) is a rare type of ovarian cancer that has an appearance similar to urothelial carcinoma (also known as transitional cell carcinoma).[1]
Diagnosis
TCC of the ovary is diagnosed by examination of the tissue by a pathologist. It has a characteristic appearance under the microscope and distinctive pattern of immunostaining.[2]
Pathology
It is not related urothelial carcinoma.[1] It is in the transitional cell category of ovarian tumours which also includes malignant Brenner tumour and benign Brenner tumour.
-
 Low mag.
Low mag. -
Very high mag.
Very high mag.
Treatment
The main treatment is surgical resection.[1]
Prognosis
These tumours do better than other types of epithelial tumours of the ovary.[1]
See also
References
- ^ a b c d Tazi, EM.; Lalya, I.; Tazi, MF.; Ahellal, Y.; M'rabti, H.; Errihani, H. (2010). "Transitional cell carcinoma of the ovary: a rare case and review of literature". World J Surg Oncol. 8: 98. doi:10.1186/1477-7819-8-98. PMC 2996384. PMID 21073751.
- ^ Eichhorn, JH.; Young, RH. (Apr 2004). "Transitional cell carcinoma of the ovary: a morphologic study of 100 cases with emphasis on differential diagnosis". Am J Surg Pathol. 28 (4): 453–63. doi:10.1097/00000478-200404000-00004. PMID 15087664. S2CID 6746881.